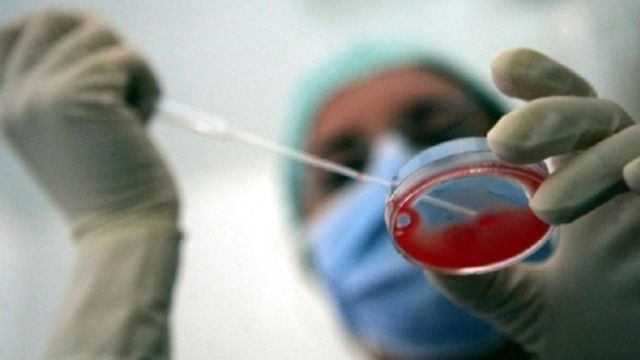
© ansa

Le autorità sanitarie canadesi hanno confermato il primo decesso (avvenuto il 3 gennaio) causato dall'influenza aviaria H5N1 nel Nord America. Il ministro della Sanità canadese, Rona Ambrose, ha riferito che la vittima, della quale non è stata resa nota l'identità, abitava nella provincia di Alberta e di recente era rientrata da un viaggio in Cina. Il ministro ha parlato di un "caso isolato", definendo basso il rischio di contagio per la popolazione.
Continua a leggere su tgcom24